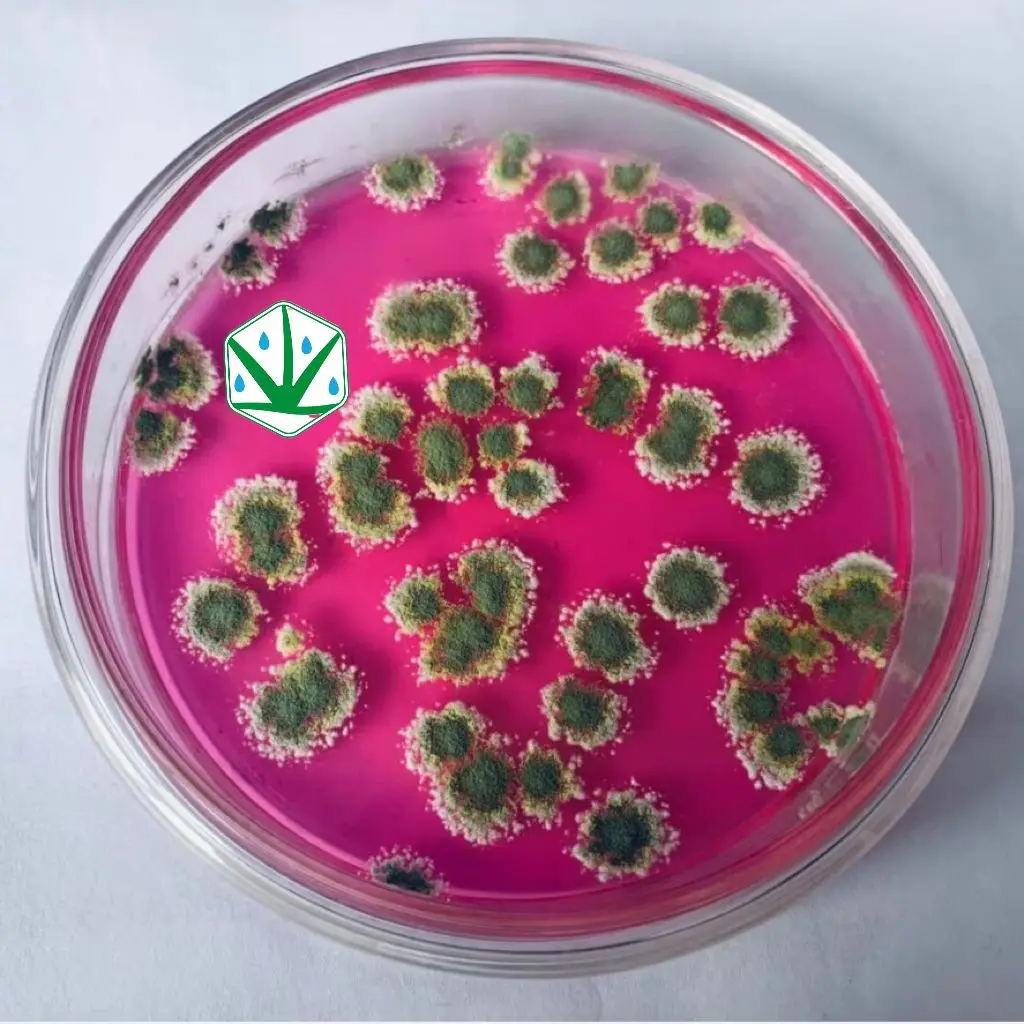

Share on (1600435264965):

1)competition | Trichoderma harzianum grows rapidly around plant roots and leaves, preempting the planting sites on the surface of the plant, forming a protective layer on the surface of the plant, preventing pathogenic microorganisms from contacting the root system and the surface of the leaves, so as to protect plants and roots from Infection by pathogenic bacteria. |
2)Parasitism | Trichoderma harzianum secretes certain metabolites to make it grow toward the host. Once the host is recognized by Trichoderma harzianum, a parasitic relationship will be established, and Trichoderma harzianum will use the host as vegetative growth and reproduction, thereby causing the bacteria to disintegrate and die. |
3)Antibiotic effect | During the growth process, Trichoderma harzi can also secrete some antimicrobial substances to prevent the colonization of pathogenic bacteria. These substances can directly inhibit the growth and reproduction of pathogenic bacteria. |
4)Induce plant resistance | The colonization of Trichoderma harzianum in the plant rhizosphere and the secretion of various plant elicitor analogs during its growth can induce the activation of the plant's anti-epidemic system, thereby protecting the plant from being infected by a large number of pathogenic microorganisms. |
5)Additional | In addition to the biological control function, Trichoderma harzianum can also promote the growth of crops: this is mainly due to the role of some secondary metabolites produced by Trichoderma harzianum, these substances mainly include: auxin, gibberellin, Cytokinin, abscisic acid, etc. |






New products from manufacturers at wholesale prices